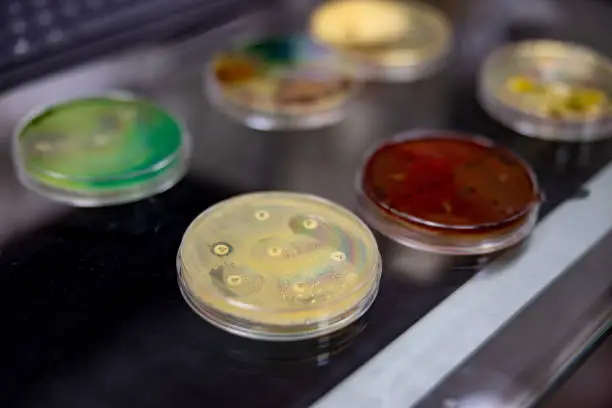
Salmonella Shigella (SSA)

Your Premium
Research Partner
in Africa
Shop Now
16 Products

₦7,500

₦3,750

₦1,500

₦750

₦7,500

₦3,750

₦3,750
₦3,750

₦3,750

₦1,500

₦3,750

₦3,750

₦3,750



